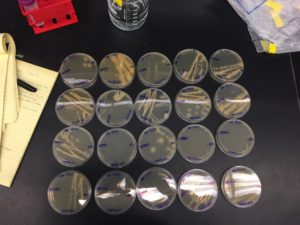
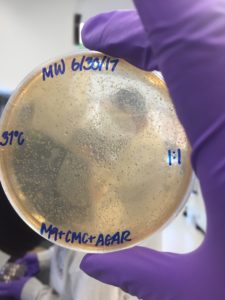
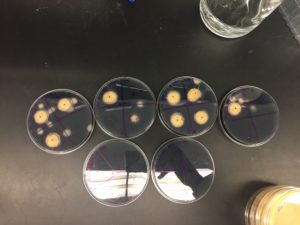

Monday, July 3, 2017
 On Monday we started off our morning preparing DNS reactant, LB+CMC liquid media, and LB+CMC+Agar media that will be used later in the week for our congo red assay. We went into the media room and each group was responsible for preparing their own media. For the DNS reactant we first had to mix the two solutions that will make the final product. One of the solutions consisted of DNS (dinitrosalicylic acid) which has a bright neon orange color and NaOH (sodium hydroxide). The second solution, which was the one I made, had Sodium potassium tartrate and water which is relatively the same solution combined to make emergency ice packs, so SUPER COLD!! We also prepared our LB+CMC solution which is shown. A little bit later we went to the lab, mixed our DNS+NaOH and Sodium potassium tartrate, and were on our way to the warm room to look at our bacteria that was isolated last week and had been growing over the weekend. We were so excited to see the growth. For some of my plates I had very little growth in the 30 degree room but as you can see in the pictures, in the 37 degree room I had tons of big and different bacteria which was really cool to see. Tuesday was 4th of July so we had a little break before the big experiments happened.
On Monday we started off our morning preparing DNS reactant, LB+CMC liquid media, and LB+CMC+Agar media that will be used later in the week for our congo red assay. We went into the media room and each group was responsible for preparing their own media. For the DNS reactant we first had to mix the two solutions that will make the final product. One of the solutions consisted of DNS (dinitrosalicylic acid) which has a bright neon orange color and NaOH (sodium hydroxide). The second solution, which was the one I made, had Sodium potassium tartrate and water which is relatively the same solution combined to make emergency ice packs, so SUPER COLD!! We also prepared our LB+CMC solution which is shown. A little bit later we went to the lab, mixed our DNS+NaOH and Sodium potassium tartrate, and were on our way to the warm room to look at our bacteria that was isolated last week and had been growing over the weekend. We were so excited to see the growth. For some of my plates I had very little growth in the 30 degree room but as you can see in the pictures, in the 37 degree room I had tons of big and different bacteria which was really cool to see. Tuesday was 4th of July so we had a little break before the big experiments happened.
Wednesday, July 5, 2017
Wednesday was all about separating our bacteria into quadrants on out LB+CMC+Agar plates and re-streaking our bacteria. For each bacteria we had to dot the different bacteria from each of our 20 colonies, put it in its corresponding quadrant and re-streak the bacteria just in case we need it later for further research. This process took a really long time!! The bacteria was placed on the LB+CMC+Agar plates in order for the bacteria to not only have a sugar source (CMC) but it was also in preparation for identifying halos which we learned more about on Thursday.
Thursday, July 6, 2017
This morning we attempted to have a friendly competition lead by Teacher Assistant Ron on molar mass problems but it shortly ended with a lot of confused iCLEM kids. In order to clear up all confusion and become molar mass experts, Ron lead us into a lecture on how to solve these kinds of problems step by step and even gave us a few different problems to solve. We then learned about DNS, reducing sugars, and DNS assay. Finally we had our last lecture lead by Teacher Assistant Virginia, sharing everything we need to know about spectrophotometry. Talk about a lecture morning!! Using all of our new knowledge we quickly went into the lab and did a plate reader practice activity and a DNS positive and negative control activity which I think was everybody’s favorite part this week so far because of all the different colors produced in the end. DNS definitely got some fame today through all the pictures we were taking.
Friday, July 7, 2017
 Woop Woop, its Friday!! Today we practically lived in the lab. We got our LB+CMC+AGAR plates that had been growing for the past two days and dyed them with congo red. Congo red is a dye used in labs which binds to cellulose. As I mentioned earlier, small or big halos might be produced if you’re bacteria has the enzyme called cellulase (an enzyme that eats cellulose) because the Congo red could not bind to the cellulose that has disappeared to the bacteria “stomach”. We started off circling our bacteria and adding our congo red to our plate. We put on the shake for a good 30-40 min just so it can get the full treatment. After the dying process went through a series of washes using NaCl (salt water) and added 1% HCl which made it a dark purple color. We were finally able to see our halos and record our observations and measurement of the halos. Sadly a lot of people had either very little or no result but I had a lot of success as well as my partner. 16/20 of my bacteria had halos!! After lunch, we had a special presentation on forensic science and went right back to the lab. The students that had successful halos gladly shared their plates and transferred our successful bacteria into our liquid LB+CMC liquid media and put it the warm rooms to get their shake on over the weekend. Week 3 is over and ready to get into Week 4.
Woop Woop, its Friday!! Today we practically lived in the lab. We got our LB+CMC+AGAR plates that had been growing for the past two days and dyed them with congo red. Congo red is a dye used in labs which binds to cellulose. As I mentioned earlier, small or big halos might be produced if you’re bacteria has the enzyme called cellulase (an enzyme that eats cellulose) because the Congo red could not bind to the cellulose that has disappeared to the bacteria “stomach”. We started off circling our bacteria and adding our congo red to our plate. We put on the shake for a good 30-40 min just so it can get the full treatment. After the dying process went through a series of washes using NaCl (salt water) and added 1% HCl which made it a dark purple color. We were finally able to see our halos and record our observations and measurement of the halos. Sadly a lot of people had either very little or no result but I had a lot of success as well as my partner. 16/20 of my bacteria had halos!! After lunch, we had a special presentation on forensic science and went right back to the lab. The students that had successful halos gladly shared their plates and transferred our successful bacteria into our liquid LB+CMC liquid media and put it the warm rooms to get their shake on over the weekend. Week 3 is over and ready to get into Week 4.